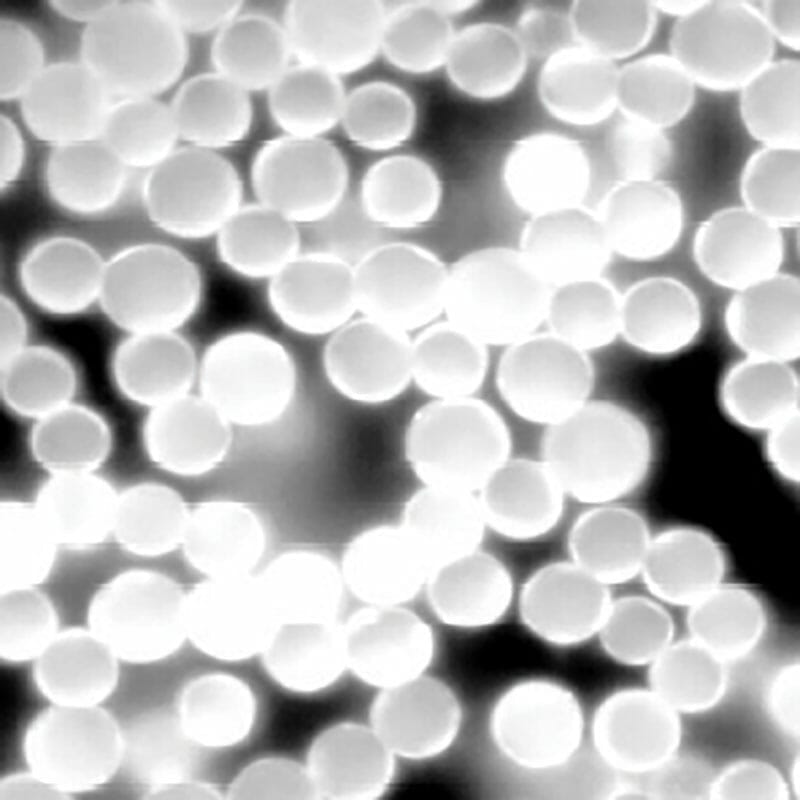
KANOMAX Fluostar Fluorescent Particles

KANOMAX Fluostar Fluorescent Particles
0.00 ฿
Unit price
/
Unavailable
KANOMAX Fluostar Fluorescent Particles is backordered and will ship as soon as it is back in stock.
ลูกค้าของคุณ...อาจกำลังดูหน้านี้อยู่
พื้นที่โฆษณานี้คือจุดที่ช่างและวิศวกรกว่า 100,000+ คน เข้ามาค้นหาสินค้าทุกวัน
ร่วมเป็น Partner กับเรา — แสดงสินค้าและบริการของคุณบน inztru.com
เพิ่มการมองเห็น สร้างโอกาสเข้าถึงลูกค้าโรงงานทั่วประเทศ
inztru by เด็กช่างวัด – แชร์ความรู้จากของจริง เชื่อมโยงอุตสาหกรรมไทย
-
Features-
-
Spec Sheets-
-
Manuals-
- Moderate size dispersity
- Uniform spherical shape
- No swelling or shrinking
- Minimal photobleaching
- Minimal dye leaking
Documents